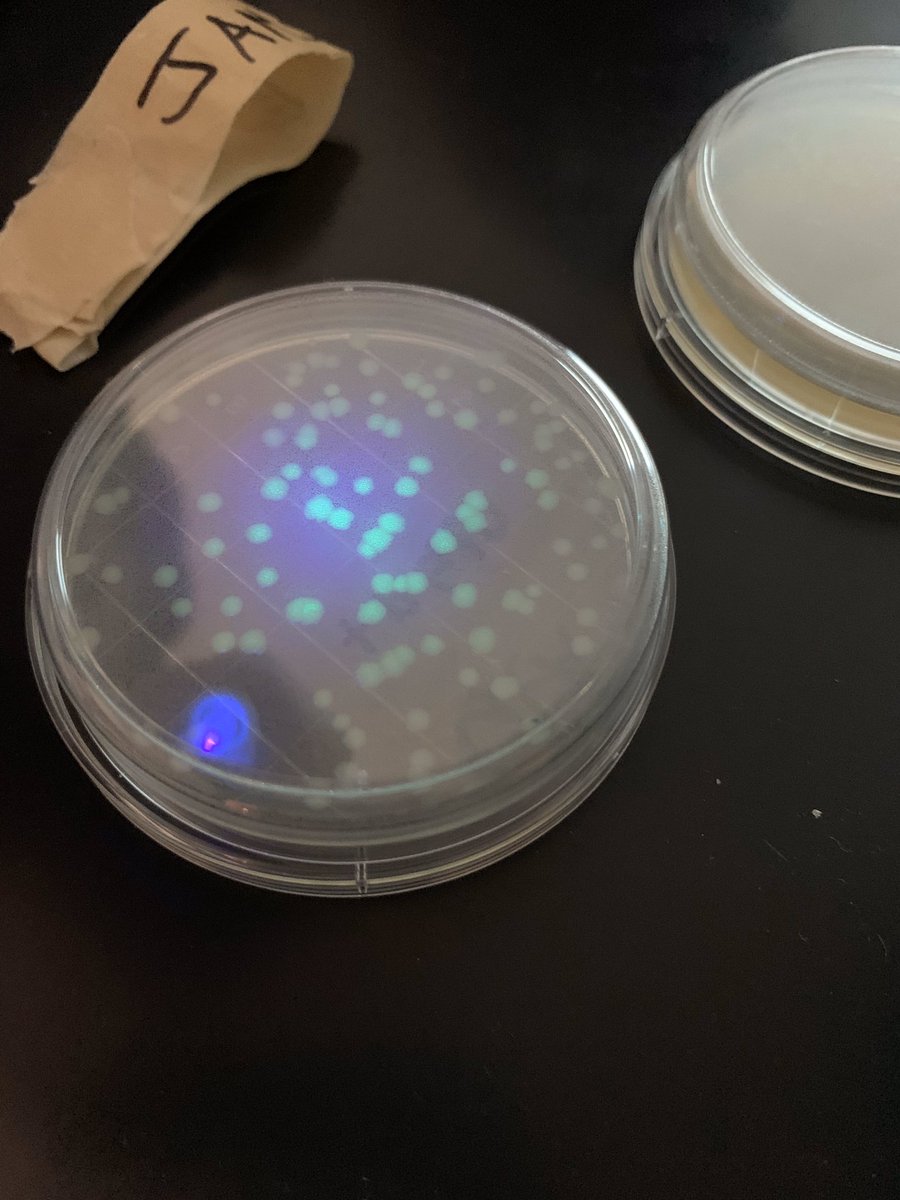

CRHS_Science
@crhs_science
ID: 1173610657318612992
http://www.katyisd.org/campus/crhs/Pages/default.aspx 16-09-2019 14:53:01
32 Tweet
48 Followers
78 Following





AP Bio bacterial transformation plates are looking good! Students took a glow gene from a jellyfish and put it in a bacterial cell! Look at them glow! #crhs #katyisdscience #cpoe Sherri Wagner

Students in AP Bio are working in groups looking at scenarios to determine the correct type of graph and identify the variables. Sherri Wagner Tina Hovance #cpoe #iamcinco


Students in chemistry working hard on their CER posters to share their lab data to determine if density is an extensive or intensive property. Tina Hovance #iamcinco


Cinco Ranch High School Chemistry Ss are testing their knowledge of lab equipment w/ a few rounds of BINGO 🧪🥼⚛️CRHS_Science Tina Hovance #CPOE #KISDscience #STEMeducation #Chemistry


Cinco Ranch High School Chem Ss exploring intensive & extensive properties with chocolate 🤎🍫🤎 Tina Hovance CRHS_Science HERSHEY'S #KISDscience #density #STEMeducation #teachersoftwitter #ScienceTwitter


Cinco Ranch High School AP Bio Ss are exploring how different salinities affect hatch rates of brine shrimp 🧡🦐🧡 Sherri Wagner Tina Hovance CRHS_Science #KISDscience #APBIO #STEMeducation #ScienceTwitter #scienceteacher #Science

CRHS_Science Bio team was hard at work digging through their Unit 1 test data. We got amazing visual snapshots of what we can focus on as we spiral content throughout the year 🧫🧬🔬 #CPOE #KISDscience #data #Biology #ScienceTwitter #scienceteacher Tina Hovance Dr. Kaye Williams


I spy an amazing science teacher 🥼🧬🧫 Thank you, Carlos, for always showing kids the science all around them! #KISDscience #CPOE CRHS_Science

AP Bio students looking for patterns in order to sort molecules into the 4 macromolecule groups. CRHS_Science Kim S⌬ares Tina Hovance


Cinco Ranch High School Forensics Ss are investigating crime scenes 🩸🔪☠️ Tina Hovance Laurie Kerley CRHS_Science Dr. Kaye Williams #KISDscience #Forensics #CSI


Come and join our Cinco Ranch Family! #cpoe CRHS PTSA CRHS Counselors Cinco Ranch FFA Cinco Ranch High School Choir







